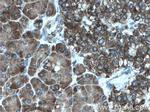
CDK5RAP3 Antibody in Immunohistochemistry (Paraffin) (IHC (P))

Search
Proteintech
CDK5RAP3 Polyclonal Antibody
{{$productOrderCtrl.translations['antibody.pdp.commerceCard.promotion.promotions']}}
{{$productOrderCtrl.translations['antibody.pdp.commerceCard.promotion.viewpromo']}}
{{$productOrderCtrl.translations['antibody.pdp.commerceCard.promotion.promocode']}}: {{promo.promoCode}} {{promo.promoTitle}} {{promo.promoDescription}}. {{$productOrderCtrl.translations['antibody.pdp.commerceCard.promotion.learnmore']}}
产品信息
11007-1-AP
种属反应
宿主/亚型
分类
类型
抗原
偶联物
形式
浓度
规格
纯化类型
保存液
内含物
保存条件
运输条件
产品详细信息
Immunogen sequence: MEDHQHVPI DIQTSKLLDW LVDRRHCSLK WQSLVLTIRE KINAAIQDMP ESEEIAQLLS GSYIHYFHCL RILDLLKGTE ASTKNIFGRY SSQRMKDWQE IIALYEKDNT YLVELSSLLV RNVNYEIPSL KKQIAKCQQL QQEYSRKEEE CQAGAAEMRE QFYHSCKQYG ITGENVRGEL LALVKDLPSQ LAEIGAAAQQ SLGEAIDVYQ ASVGFVCESP TEQVLPMLRF VQKRGNSTVY EWRTGTEPSV VERPHLEELP EQVAEDAIDW GDFGVEAVSE GTDSGISAEA AGIDWGIFPE S (1-300 aa encoded by BC009957)
靶标信息
This gene encodes a protein that has been reported to function in signaling pathways governing transcriptional regulation and cell cycle progression. It may play a role in tumorigenesis and metastasis. A pseudogene of this gene is located on the long arm of chromosome 20. Alternative splicing results in multiple transcript variants that encode different isoforms. [provided by RefSeq, May 2013].
仅用于科研。不用于诊断过程。未经明确授权不得转售。
生物信息学
蛋白别名: CDK5 activator-binding protein C53; CDK5 regulatory subunit associated protein IC53-2; CDK5 regulatory subunit-associated protein 3; IC53-2; ischemic heart CDK5 activator-binding protein C53; LXXLL/leucine-zipper-containing ARF-binding protein; LXXLL/leucine-zipper-containing ARFbinding protein; OK/SW-cl.114; Protein HSF-27; unnamed protein product
基因别名: C53; CDK5RAP3; HSF-27; IC53; LZAP; MST016; MSTP016; OK/SW-cl.114; PP1553
UniProt ID: (Human) Q96JB5
Entrez Gene ID: (Human) 80279